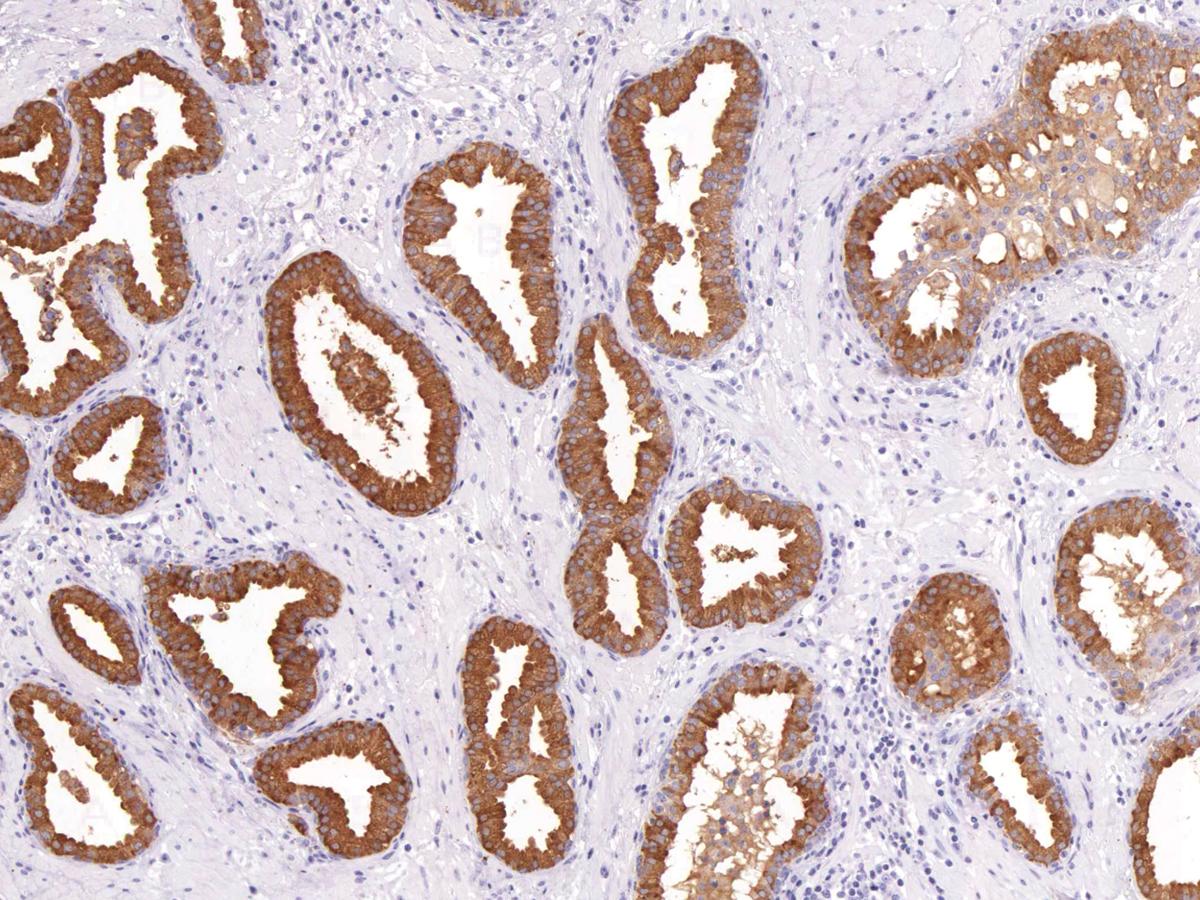

Anti-PSA Monoclonal Antibody (Clone:IHC654)
Figure 1: Immunohistochemical analysis of PSA (Clone: IHC654) on Prostate
Roll over image to zoom in
Shipping Info:
For estimated delivery dates, please contact us at [email protected]
Format : | Purified |
Amount : | 0.5 ml |
Purification : | Protein A/G Chromatography |
Content : | Tris Buffer, pH 7.3 - 7.7, with 1% BSA and <0.1% Sodium Azide |
Storage condition : | Store at 2°C - 8°C. Do not freeze. |
Prostate-Specific Antigen (PSA) is a serine protease of the kallikrein family, that is produced by the prostate epithelium and epithelial lining of the periurethral glands. Although considered prostate-specific, PSA has also been detected in breast tissue, breast tumors, endometrium, adrenal neoplasms, and renal cell carcinomas. Anti-PSA can be used for differentiating high-grade prostate adenocarcinoma from high-grade urothelial carcinoma, as well as for determining the prostatic origin of carcinomas in non-prostate tissues. Anti-PSA recognizes primary and metastatic prostatic neoplasms, but not tumors of nonprostatic origin, and can be useful as an aid to confirm prostatic acinar cell origin in primary and metastatic carcinomas.
Recommended dilutions: Immunohistochemical analysis: 1:100 - 1:200. However, this need to be optimized based on the research applications.
For Research Use Only. Not for use in diagnostic/therapeutics procedures.
Subcellular location: | Secreted |
BioGrid: | 106850. 9 interactions. |
There are currently no product reviews
|